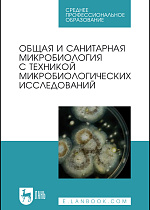
Общая и санитарная микробиология с техникой микробиологических исследований, Лабинская А. С., Блинкова Л. П., Ещина А. С., Булава Г.В., Вертиев Ю.В., Винокуров А.Е., Горобец О. Б., Дарбеева О.С., Жиленков Е.Л., Зверьков Д.А., Иванова С. М., Ильина Т.С., Корн М.Я., Кривопалова Н.С., Лукин И.Н., Мельникова В.А., Нехорошева А.Г., Романова Ю.М., Сидоренко С.В., Скаженик В.Ю., Скала Л.З., Трухина Г.М., Издательство Лань.

Основы микробиологии - все книги по дисциплине. Издательство Лань
Сохранить список:
Excel
Excel
Закрыть
Выгрузка списка книг доступна только авторизованным пользователям. Авторизоваться
В учебном пособии представлены материалы по технологии работы с биоматериалами в лаборатории, предназначенными для проведения ветеринарно-санитарных исследований.
Учебное пособие разработано на основе Федерального государственного образовательного стандарта начального профессионального образования по профессии «Лаборант в области ветеринарии».
Соответствует современным требованиям Федерального государственного образовательного стандарта среднего профессионального образования и профессиональным квалификационным требованиям.
Учебное пособие разработано на основе Федерального государственного образовательного стандарта начального профессионального образования по профессии «Лаборант в области ветеринарии».
Соответствует современным требованиям Федерального государственного образовательного стандарта среднего профессионального образования и профессиональным квалификационным требованиям.
Учебное пособие к лабораторно-практическим занятиям содержит краткие сведения по изучаемым темам, методические указания по выполнению работ, постановке опытов. Обозначенные в пособии методические установки позволяют систематизировать знания по микробиологии. Каждая тема снабжена контрольными вопросами, рекомендована литература по пройденной теме. Учебное пособие предназначено для студентов, обучающихся по направлениям подготовки «Агрономия» и «Садоводство», его можно рекомендовать и специалистам, самостоятельно изучающим микробиологию.
Данное издание подготовлено по дисциплине «Микробиология» в соответствии с Федеральным государственным образовательным стандартом высшего образования (ФГОС ВО) по направлениям подготовки «Агрономия», "Садоводство".
Данное издание подготовлено по дисциплине «Микробиология» в соответствии с Федеральным государственным образовательным стандартом высшего образования (ФГОС ВО) по направлениям подготовки «Агрономия», "Садоводство".
Учебное пособие состоит из пяти разделов. В первом разделе изложены вопросы общей микробиологии: описаны морфология, строение, физиология, экология, наследственность и изменчивость микроорганизмов, а также превращения микроорганизмами соединений азота и углерода, формы взаимоотношений в мире микробов, антибиотики, влияние факторов внешней среды на микроорганизмы. Второй раздел посвящен учению об инфекции и иммунитете. В третьем разделе описаны возбудители инфекционных болезней животных. В четвертом разделе рассматриваются вопросы о микробиологии продуктов и сырья животного происхождения, кормов и навоза. Пятый раздел — лабораторные занятия — посвящен микробиологическим и серологическим методам диагностики инфекционных болезней животных, санитарно-микробиологическим методам исследования воздуха, воды, молока, молочных продуктов, мяса и кормов.
Соответствует современным требованиям Федерального государственного образовательного стандарта среднего профессионального образования и профессиональным квалификационным требованиям.
Учебное пособие предназначено для студентов, получающих среднее профессиональное образование.
Соответствует современным требованиям Федерального государственного образовательного стандарта среднего профессионального образования и профессиональным квалификационным требованиям.
Учебное пособие предназначено для студентов, получающих среднее профессиональное образование.
В учебнике рассмотрены вопросы развития микробиологии молока и молочных продуктов, современные представления о классификации и свойствах микроорганизмов, применяемых в производстве молочных продуктов, а также вызывающих их порчу и алиментарные заболевания. Дана характеристика индикаторных групп микроорганизмов, позволяющих контролировать качество и безопасность молочных продуктов. Описаны особенности микробиологических процессов и контроля производства сырого и питьевого молока, кисломолочных продуктов, сыра, масла, вторичного молочного сырья, молочных консервов и мороженого в соответствии с действующими нормативными документами.
Соответствует современным требованиям Федерального государственного образовательного стандарта среднего профессионального образования и профессиональным квалификационным требованиям.
Учебник предназначен для студентов техникумов и колледжей, обучающихся по специальности «Технология продуктов питания животного происхождения » и практикующих специалистов.
Соответствует современным требованиям Федерального государственного образовательного стандарта среднего профессионального образования и профессиональным квалификационным требованиям.
Учебник предназначен для студентов техникумов и колледжей, обучающихся по специальности «Технология продуктов питания животного происхождения » и практикующих специалистов.
Приводятся современные данные биохимических процессов, вызываемых микроорганизмами в аквасреде, рассматриваются влияние экологических факторов на микроорганизмы, инфекции и иммунитет, патогенная микрофлора, передающаяся через воду, санитарно микробиологическая характеристика и оценка качества сточных и природных вод, зоны сапробности, микробиологические основы очистки, самоочищения природных и сточных вод, бактериальная продукция и методы ее определения, роль микроорганизмов в повышении рыбопродуктивности аквасреды, микрофлора живой рыбы.
Соответствует современным требованиям Федерального государственного образовательного стандарта среднего профессионального образования и профессиональным квалификационным требованиям.
Учебник предназначен для студентов колледжей и техникумов.
Соответствует современным требованиям Федерального государственного образовательного стандарта среднего профессионального образования и профессиональным квалификационным требованиям.
Учебник предназначен для студентов колледжей и техникумов.
Учебное пособие состоит из двух частей. В первой части приведены современные данные по общей микробиологии, изложены материалы о роли микроорганизмов в технологии производства и переработке сельскохозяйственной продукции, принципы и методы санитарно-микробиологических исследований продуктов животного происхождения: мяса, яиц, молока и продуктов их переработки, а также рассмотрены основные положения учения об инфекции и иммунитете; микрофлора и микробиология почвы, навоза, эпифитная микрофлора плодов и овощей, бродильных производств, таких как пивоварение, виноделие, получение уксуса; описаны микробиологические процессы при производстве сена, силоса, сенажа и дрожжевании кормов. Во второй части «Лабораторные занятия» — приведены методы микробиологического контроля качества готовой продукции и сырья животного происхождения. В конце книги приведен словарь специальных терминов и тестовые задания.
Соответствует современным требованиям Федерального государственного образовательного стандарта среднего профессионального образования и профессиональным квалификационным требованиям.
Учебное пособие предназначено для студентов техникумов и колледжей.
Соответствует современным требованиям Федерального государственного образовательного стандарта среднего профессионального образования и профессиональным квалификационным требованиям.
Учебное пособие предназначено для студентов техникумов и колледжей.
В первой части учебного пособия изложены основные сведения о морфологии, физиологии и экологии микроорганизмов, основы инфекции и инфекционного процесса, иммунитета и о санитарно-показательных микроорганизмах. Содержатся материалы о ветеринарной санитарии и гигиене, значение гигиены в охране здоровья животных и личная гигиена работников животноводства, а также о дезинфекции, дезинсекции и дератизации в животноводческих хозяйствах и на мясо- молокоперерабатывающих предприятиях. Также уделено внимание микрофлоре пищевых продуктов и профилактике микотоксикозов кормов.Во второй части учебного пособия изложены темы лабораторных занятий: общие правила отбора, консервирования и пересылки проб продуктов животного происхождения для микробиологических исследований, контроль качества дезинфекции и микробиологические исследования воды, почвы и воздуха.Настоящее учебное пособие разработано на основе Федерального государственного образовательного стандарта среднего профессионального образования по дисциплине «Микробиология, санитария и гигиена», примерной программы учебной дисциплины, является частью ППССЗ в соответствии с ФОГС по специальности «Зоотехния» СПО (базовый уровень подготовки).
Учебник состоит из трех разделов. В первом разделе изложены сведения по морфологии, физиологии, генетике и экологии микроорганизмов, описано значение микроорганизмов в природе, жизни человека и животных, а также превращения микроорганизмами соединений азота и углерода, формы взаимоотношений в мире микробов, антибиотики, влияние факторов внешней среды на микроорганизмы. Второй раздел посвящен основам учения об инфекции и иммунитете, понятиям патогенности и вирулентности.Третий раздел — лабораторные занятия — посвящен микробиологическим, культуральным, биохимическим методам исследования, правилам отбора, доставки и хранения биоматериала и серологическим методам диагностики инфекционных болезней животных.
Соответствует современным требованиям Федерального государственного образовательного стандарта среднего профессионального образования и профессиональным квалификационным требованиям.
Предназначен для студентов СПО.
Соответствует современным требованиям Федерального государственного образовательного стандарта среднего профессионального образования и профессиональным квалификационным требованиям.
Предназначен для студентов СПО.
В пособии освещены вопросы общей и санитарной микробиологии. Описаны требования по технике безопасности, методы дезинфекции и стерилизации, манипуляции с экспериментальными животными. Дана информация об оснащении бактериологической лаборатории и методах микробиологии, технике выращивания и изучения микроорганизмов в живом и окрашенном состоянии, приготовлении питательных сред, изучении антибиотикоустойчивости, дифференциально-диагностическом тестировании. Включен материал по бактериофагам, генетике бактерий, идентификации микроорганизмов с помощью ПЦР, об иммунитете и методах его оценки. Особое место занимают главы о физиолого-биохимических свойствах микроорганизмов и современных технологиях, применяемых в клинической микробиологии. Рассмотрены основные задачи и методы санитарно-микробиологических исследований воды, почвы, воздуха, пищевых продуктов, перевязочных средств и т. д.
Соответствует современным требованиям Федерального государственного образовательного стандарта среднего профессионального образования и профессиональным квалификационным требованиям.
Соответствует современным требованиям Федерального государственного образовательного стандарта среднего профессионального образования и профессиональным квалификационным требованиям.
В учебном пособии представлены основы общей микробиологии, правила отбора, подготовки к исследованию продуктов животного происхождения для микробиологических исследований: бактериологическое исследование мяса животных и птиц, мясных консервов и сырья для изготовления колбасных изделий; бактериологическая оценка качества яиц и молока, рыбных консервов, рыбы и морепродуктов, а также зерна, муки и хлебных продуктов.
Соответствует современным требованиям Федерального государственного образовательного стандарта среднего профессионального образования и профессиональным квалификационным требованиям.
Учебное пособие предназначено для студентов колледжей и техникумов, а также будет полезно для специалистов данной отрасли.
Соответствует современным требованиям Федерального государственного образовательного стандарта среднего профессионального образования и профессиональным квалификационным требованиям.
Учебное пособие предназначено для студентов колледжей и техникумов, а также будет полезно для специалистов данной отрасли.
Закрыть
Сообщить о поступлении
Укажите ваш e-mail, и мы пришлем уведомление, как только книга
станет доступна для покупки.